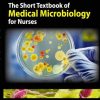

The Violence of Care Rape Victims Forensic Nurses and Sexual Assault Intervention
₨ 1,500 Original price was: ₨ 1,500.₨ 1,300Current price is: ₨ 1,300.
Colour Matt Finshed
ISBN N/A
Category: Nursing Books
Tags: NURSING BOOKS IN HYDERABAD, NURSING BOOKS IN ISLAMABAD, NURSING BOOKS IN KARACHI, NURSING BOOKS IN LAHORE, NURSING BOOKS IN MULTAN, NURSING BOOKS IN PAKISTAN, NURSING BOOKS IN PESHAWAR, NURSING BOOKS IN QUETTA, NURSING BOOKS IN RAWALPINDI, TAGS: NURSING BOOKS IN FAISLABAD
Only logged in customers who have purchased this product may leave a review.
Related products
Sale!
Nursing Books
ISBN 9781284129175
₨ 80 Original price was: ₨ 80.₨ 20Current price is: ₨ 20.
Sale!
Nursing Books
ISBN 9780190204747
₨ 150 Original price was: ₨ 150.₨ 30Current price is: ₨ 30.
Sale!
Nursing Books
A Practical Guide to Forensic Nursing Incorporating Forensic Principles into Nursing Practice
ISBN 9781940446349
₨ 75 Original price was: ₨ 75.₨ 20Current price is: ₨ 20.
Sale!
ISBN 9781938904820
₨ 75 Original price was: ₨ 75.₨ 15Current price is: ₨ 15.
Sale!
ISBN 9781451190359
₨ 75 Original price was: ₨ 75.₨ 20Current price is: ₨ 20.
Sale!
Nursing Books
ISBN 9781119439097
₨ 75 Original price was: ₨ 75.₨ 20Current price is: ₨ 20.
Sale!
ISBN 9781609137113
₨ 100 Original price was: ₨ 100.₨ 40Current price is: ₨ 40.
Sale!
ISBN 9780803666610
₨ 75 Original price was: ₨ 75.₨ 25Current price is: ₨ 25.

Reviews
There are no reviews yet.